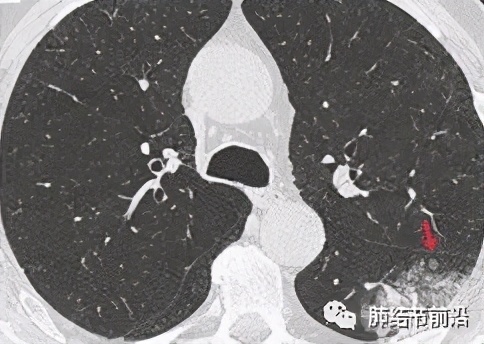
肺癌气道播散转移的症状,肺癌胸膜腔转移

专家简介:张勇,复旦大学附属中山医院呼吸科副主任医师、博士。擅长肺部结节的人工智能(AI)良恶性鉴别、疑难肺部结节的鉴别诊断、肺部磨玻璃结节(GGN)的定性与分级(腺瘤增生-原位癌-微浸润-浸润性腺癌)、肺部磨玻璃结节的浸润风险评估,手术时机的选择、肺部结节的磁导航支气管镜活检及微创消融、肺部肿瘤的诊治(靶向,免疫,放化疗)。
肺癌的肺泡间转移(Spread through air spaces,STAS),为WHO2015年最新确认的一种肺癌的扩散方式。STAS定义为在肺癌主病灶之外的周围肺泡腔内存在肿瘤细胞。为肺癌除外淋巴转移,血液转移和局部直接转移之后的第4种转移方式。STAS因会显著增加早期肺癌术后的复发率因而备受关注。如果早期肺癌术后病理存在STAS,即为浸润性腺癌的(IAC)的范畴。换句话说,原位癌(AIS)和微浸润腺癌(MIA)是不会出现STAS的。

STAS的病理图:为肿瘤细胞脱落于主病灶。可以单个,也可为多个。
SATS的临床特征:
总的来说,STAS可见于14.8-60.5%的非小细胞肺癌,绝大多数为腺癌。STAS也可多种分类:根据离主病灶的距离,侵犯肺泡数和形态学特点。STAS与主病灶的距离有:0.2至8.5mm(约1-58个肺泡);离主病灶3个肺泡之内/或之外。STAS也可按照转移细胞数量分为少量STAS(1–4 个细胞或集落) 和高数量STAS(> 5个单个细胞或集落)。STAS很少发生于贴壁样生长的肺腺癌,多见于分化较差的病理类型,即微乳头和实体型腺癌以及筛状腺泡型。STAS与更差的肿瘤分期,淋巴结转移,血管侵犯,胸膜侵犯和远处转移相关,并可能多见于男性吸烟者。
由此可见,部分STAS在CT上的表现为肺泡转移病灶靠近原发病灶的1cm之内。衍生出一个问题:多发GGO认为是多原发,而不是STAS转移。
STAS对肺癌分期影响:
STAS目前尚未被列入8th肺癌TNM分期。但STAS会影响IA期肺癌术后的预后,伴有STAS的IA期肺癌术后的预后和IB期相似。并主要在肿瘤直径2-3cm(IA3期)的患者有生存期的影响。由于其对预后的影响和侵犯脏层胸膜相似,可能今后将STAS列入TNM分期中的T2。即目前伴有STAS的IA期肺癌,今后可能被归为IB期。
STAS对治疗的指导:
对于早期肺癌,肺叶切除仍然是标准方案。然而临床上对于2cm以下的磨玻璃结节,越来越多的证据显示亚肺叶切除是足够的。但对于伴有STAS 的早期肺癌,肺叶切除则是强烈推荐的。多个回顾性研究证实,对于伴有STAS的肺癌患者,亚肺叶切除后比肺叶切除复发率明显升高。目前的指南对IA期肺癌患者术后辅助治疗是完全不必要的。那么,伴有STAS的IA期肺癌术后是否需要辅助化疗或者靶向治疗?目前没有定论(应该说没有任何数据可供参考)。推测可能需要术后辅助治疗的人群为:IA3期,伴有STAS的微乳头/实体/筛状腺泡型腺癌患者。
另外,STAS对术中冰冻病理提出更高要求,术中冰冻最好能对有无STAS做判断,如果有STAS,则必须做肺叶切除。但临床难点是术中冰冻观察STAS难度很高,敏感性大概只有50%。
STAS的分子机制:有关STAS的分子机制研究很少。对于STAS和哪种基因突变有关,目前各研究结论不一。而也有研究显示,STAS和PD-L1的表达也并无关系。而且这些对治疗的临床意义不大,暂不讨论。
STAS的CT特点:这是重点!STAS 是一个术后的病理诊断,术前能否通过CT判断STAS的风险,可以对手术的时机和手术方式做最佳判断。如有STAS可能,则因尽早手术,并且需要做肺叶切除。 然而仅有少数情况下CT可以直接观察到,具体表现为:在主病灶周围显示不连续的转移灶。
大片混杂磨玻璃影,CT显示卫星灶,离主病灶10mm之内,为STAS
也有一些CT表现,可以间接预测STAS的可能。首先,STAS很少发生于磨玻璃结节,主要发生于实性或实性结节为主的肺结节。CT特征还有:结节有毛刺,有卫星灶,胸膜粘连,磨玻璃条带,以及不清晰的瘤-肺边界。


STAS显示为结节外侧的磨玻璃条带。

STAS显示为肺结节非常规的相邻双中心生长
如果有影像上怀疑STAS,建议早期切除。但是磨玻璃结节患者也不必紧张,对于贴壁样的磨玻璃结节,极少会有STAS出现。
总结:
STAS多见于实性/实性为主结节,磨玻璃非常少见。
原位癌和微浸润腺癌不会有STAS。
病理上,微乳头/实体/筛状腺泡型腺癌多见。
有STAS,需要肺叶切除。
STAS影响IA期患者预后(主要为IA3期患者)。
STAS今后可能会被分为TNM分期中的T2。
STAS有些可预测的CT表现,需要仔细观察。